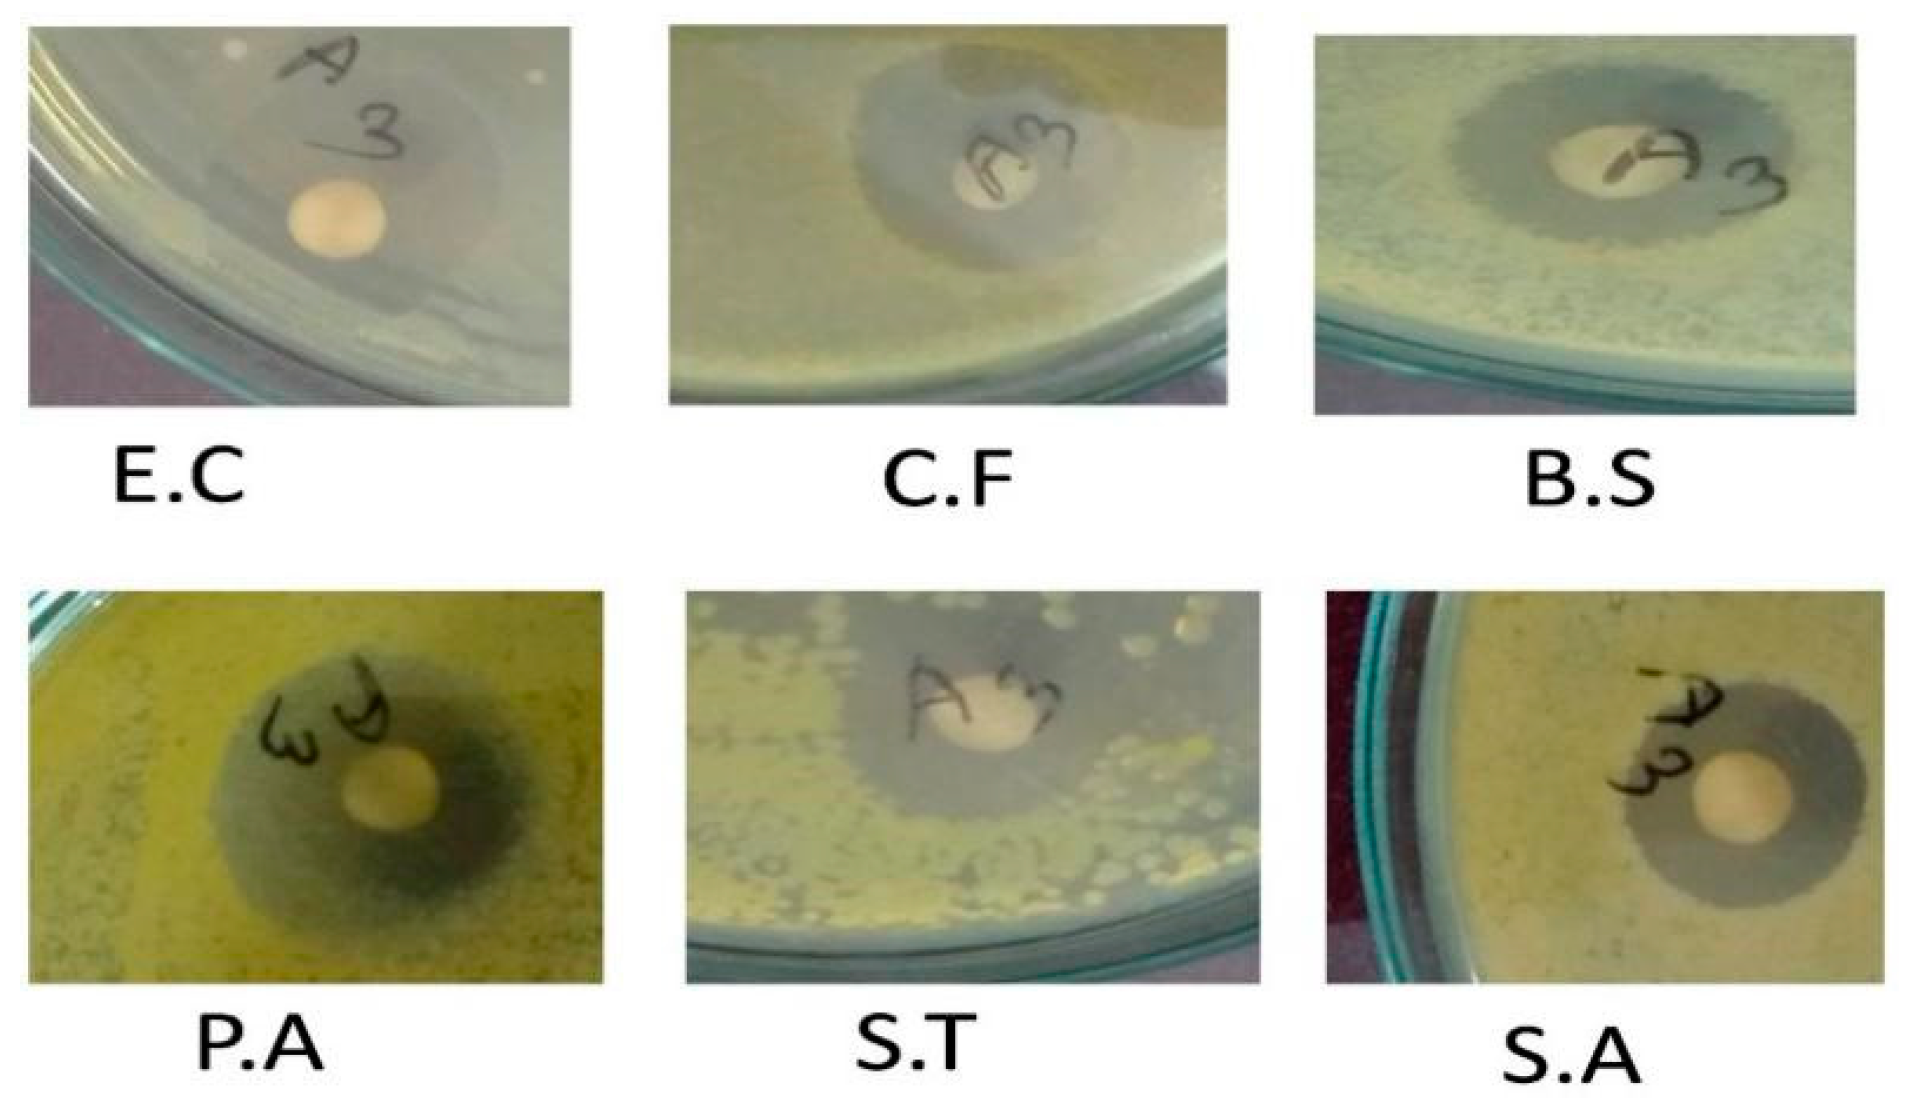
Molecules 25 04773 g005 Molecules 25 04773 g005

Green Synthesis of Gold and Silver Nanoparticles by Using Amorphophallus paeoniifolius Tuber Extract and Evaluation of Their Antibacterial Activity
Abstract
1. Introduction
2. Results and Discussion
2.1. UV-Vis Spectroscopy
2.2. X-ray Diffraction Analysis
2.3. FESEM and EDS Analysis
2.4. FTIR Analysis
2.5. Anti-Bacterial Analysis with AuNPs and AgNPs
2.6. Effect of Sunlight in AgNPs Synthesis
2.7. Probable Mechanism of AuNPs and AgNPs Formation
3. Experimental
3.1. Materials
3.2. Preparation of the Tuber Extract
3.3. Synthesis of AuNPs and AgNPs
3.4. Characterization of Synthesized AuNPs and AgNPs
3.5. Antibacterial Assay
4. Conclusions
Author Contributions
Funding
Acknowledgments
Conflicts of Interest
References
- El-Nour, K.M.A.; Eftaiha, A.; Al-Warthan, A.; Ammar, R.A. Synthesis and applications of silver nanoparticles. Arab. J. Chem. 2010, 3, 135–140. [Google Scholar] [CrossRef]
- Bollella, P.; Schulz, C.; Favero, G.; Mazzei, F.; Ludwig, R.; Gorton, L.; Antiochia, R. Green Synthesis and Characterization of Gold and Silver Nanoparticles and their Application for Development of a Third Generation Lactose Biosensor. Electroanalysis 2016, 29, 77–86. [Google Scholar] [CrossRef]
- Sulaiman, G.M.; Mohammed, W.H.; Marzoog, T.R.; Al-Amiery, A.A.A.; Kadhum, A.A.H.; Mohamad, A.B. Green synthesis, antimicrobial and cytotoxic effects of silver nanoparticles using Eucalyptus chapmaniana leaves extract. Asian Pac. J. Trop. Biomed. 2013, 3, 58–63. [Google Scholar] [CrossRef]
- Philip, D.; Unni, C.; Aromal, S.A.; Vidhu, V. Murraya Koenigii leaf-assisted rapid green synthesis of silver and gold nanoparticles. Spectrochim. Acta Part A Mol. Biomol. Spectrosc. 2011, 78, 899–904. [Google Scholar] [CrossRef] [PubMed]
- Soshnikova, V.; Kim, Y.-J.; Singh, P.; Huo, Y.; Markus, J.; Ahn, S.; Castro-Aceituno, V.; Kang, J.; Chokkalingam, M.; Mathiyalagan, R.; et al. Cardamom fruits as a green resource for facile synthesis of gold and silver nanoparticles and their biological applications. Artif. Cells Nanomed. Biotechnol. 2017, 46, 108–117. [Google Scholar] [CrossRef] [PubMed]
- Patil, M.P.; Kim, G.-D. Eco-friendly approach for nanoparticles synthesis and mechanism behind antibacterial activity of silver and anticancer activity of gold nanoparticles. Appl. Microbiol. Biotechnol. 2016, 101, 79–92. [Google Scholar] [CrossRef] [PubMed]
- Das, S.K.; Das, A.R.; Guha, A.K. Gold Nanoparticles: Microbial Synthesis and Application in Water Hygiene Management. Langmuir 2009, 25, 8192–8199. [Google Scholar] [CrossRef] [PubMed]
- Umamaheswari, C.; Lakshmanan, A.; Nagarajan, N. Green synthesis, characterization and catalytic degradation studies of gold nanoparticles against congo red and methyl orange. J. Photochem. Photobiol. B Biol. 2018, 178, 33–39. [Google Scholar] [CrossRef]
- Honary, S.; Gharaei-Fathabad, E.; Barabadi, H.; Naghibi, F. Fungus-mediated synthesis of gold nanoparticles: A novel biological approach to nanoparticle synthesis. J. Nanosci. Nanotechnol. 2013, 13, 1427–1430. [Google Scholar] [CrossRef]
- Shaik, M.R.; Khan, M.; Al-Warthan, A.; Al-Warthan, A.; Alkhathlan, H.Z.; Siddiqui, M.R.H.; Shaik, J.P.; Ahamed, A.; Mahmood, A.; Khan, M.; et al. Plant-Extract-Assisted Green Synthesis of Silver Nanoparticles Using Origanum vulgare L. Extract and Their Microbicidal Activities. Sustainability 2018, 10, 913. [Google Scholar] [CrossRef]
- Lung, J.; Huang, J.; Tien, D.; Liao, C.; Tseng, K.; Tsung, T.; Kao, W.; Tsai, T.; Jwo, C.; Lin, H.; et al. Preparation of Gold Nanoparticles by Arc Discharge in Water. J. Alloys Compd. 2007, 435, 655–658. [Google Scholar] [CrossRef]
- Aziz, A.; Kim, J.-P.; Oyama, M. Preparation of monodispersed carboxylate-functionalized gold nanoparticles using pamoic acid as a reducing and capping reagent. Gold Bull. 2014, 47, 127–132. [Google Scholar] [CrossRef]
- Smitha, S.; Philip, D.; Gopchandran, K. Green synthesis of gold nanoparticles using Cinnamomum zeylanicum leaf broth. Spectrochim. Acta Part A Mol. Biomol. Spectrosc. 2009, 74, 735–739. [Google Scholar] [CrossRef] [PubMed]
- Gomathi, M.; Prakasam, A.; Rajkumar, P.V. Green Synthesis, Characterization and Antibacterial Activity of Silver Nanoparticles Using Amorphophallus paeoniifolius Leaf Extract. J. Clust. Sci. 2019, 30, 995–1001. [Google Scholar] [CrossRef]
- Elahi, N.; Kamali, M.; Baghersad, M.H. Recent biomedical applications of gold nanoparticles: A review. Talanta 2018, 184, 537–556. [Google Scholar] [CrossRef]
- Abbasi, E.; Milani, M.; Aval, S.F.; Kouhi, M.; Akbarzadeh, A.; Nasrabadi, H.T.; Nikasa, P.; Joo, S.W.; Hanifehpour, Y.; Nejati-Koshki, K.; et al. Silver nanoparticles: Synthesis methods, bio-applications and properties. Crit. Rev. Microbiol. 2014, 42, 1–8. [Google Scholar] [CrossRef]
- Tran, Q.H.; Nguyen, V.Q.; Le, A.-T. Silver nanoparticles: Synthesis, properties, toxicology, applications and perspectives. Adv. Nat. Sci. Nanosci. Nanotechnol. 2013, 4. [Google Scholar] [CrossRef]
- Abdelghany, T.M.; Al-Rajhi, A.M.H.; Al Abboud, M.A.; AlAwlaqi, M.M.; Magdah, A.G.; Helmy, E.A.M.; Mabrouk, A.S. Recent Advances in Green Synthesis of Silver Nanoparticles and Their Applications: About Future Directions. A Review. BioNanoScience 2017, 8, 5–16. [Google Scholar] [CrossRef]
- Thomas, B.; Vithiya, B.S.M.; Prasad, T.A.A.; Mohamed, S.B.; Magdalane, C.M.; Kaviyarasu, K.; Maaza, M. Antioxidant and Photocatalytic Activity of Aqueous Leaf Extract Mediated Green Synthesis of Silver Nanoparticles Using Passiflora edulis f. flavicarpa. J. Nanosci. Nanotechnol. 2019, 19, 2640–2648. [Google Scholar] [CrossRef]
- Kumar, V.; Yadav, S.K. Plant-mediated synthesis of silver and gold nanoparticles and their applications. J. Chem. Technol. Biotechnol. 2009, 84, 151–157. [Google Scholar] [CrossRef]
- Kumar, K.P.; Paul, W.; Sharma, C.P. Green synthesis of gold nanoparticles with Zingiber officinale extract: Characterization and blood compatibility. Process. Biochem. 2011, 46, 2007–2013. [Google Scholar] [CrossRef]
- Ulug, B.; Turkdemir, M.H.; Cicek, A.; Mete, A. Role of irradiation in the green synthesis of silver nanoparticles mediated by fig (Ficus carica) leaf extract. Spectrochim. Acta Part A Mol. Biomol. Spectrosc. 2015, 135, 153–161. [Google Scholar] [CrossRef]
- Kumar, V.; Bano, D.; Mohan, S.; Singh, D.K.; Hasan, S.H. Sunlight-induced green synthesis of silver nanoparticles using aqueous leaf extract of Polyalthia longifolia and its antioxidant activity. Mater. Lett. 2016, 181, 371–377. [Google Scholar] [CrossRef]
- Sukhija, S.; Singh, S.; Riar, C.S. Effect of oxidation, cross-linking and dual modification on physicochemical, crystallinity, morphological, pasting and thermal characteristics of elephant foot yam (Amorphophallus paeoniifolius) starch. Food Hydrocoll. 2016, 55, 56–64. [Google Scholar] [CrossRef]
- Babu, A.S.; Parimalavalli, R. Functional and Chemical Properties of Starch Isolated from Tubers. Int. J. Food Sci. 2012, 2, 77–80. [Google Scholar]
- Singh, A.; Wadhwa, N. A Review on Multiple Potential of Aroid: Amorphophallus Paeoniifolius Synonyms. Int. J. Pharm. Sci. Rev. Res. 2014, 24, 55–60. [Google Scholar]
- Madhurima, P.; Kuppast, I.J.; Mankani, K.L. A Review on Amorphophallus Paeoniifolius. Int. J. Adv. Sci. Res. Technol. 2012, 2, 25–30. [Google Scholar]
- Hamelian, M.; Zangeneh, M.M.; Amisama, A.; Varmira, K.; Veisi, H. Green synthesis of silver nanoparticles using Thymus kotschyanus extract and evaluation of their antioxidant, antibacterial and cytotoxic effects. Appl. Organomet. Chem. 2018, 32, e4458. [Google Scholar] [CrossRef]
- Bonigala, B.; Kasukurthi, B.; Konduri, V.V.; Mangamuri, U.K.; Gorrepati, R.; Poda, S. Green synthesis of silver and gold nanoparticles using Stemona tuberosa Lour and screening for their catalytic activity in the degradation of toxic chemicals. Environ. Sci. Pollut. Res. 2018, 25, 32540–32548. [Google Scholar] [CrossRef]
- Gopinath, K.; Kumaraguru, S.; Bhakyaraj, K.; Mohan, S.; Venkatesh, K.S.; Esakkirajan, M.; Kaleeswarran, P.; Alharbi, N.S.; Kadaikunnan, S.; Govindarajan, M.; et al. Green synthesis of silver, gold and silver/gold bimetallic nanoparticles using the Gloriosa superba leaf extract and their antibacterial and antibiofilm activities. Microb. Pathog. 2016, 101, 1–11. [Google Scholar] [CrossRef]
- Mathew, B.; Joseph, S.; Koshy, E.P.; Mathew, B. Green synthesis and characterization of gold and silver nanoparticles using Mussaenda glabrata leaf extract and their environmental applications to dye degradation. Environ. Sci. Pollut. Res. 2017, 24, 17347–17357. [Google Scholar] [CrossRef]
- Joseph, S.; Mathew, B. Microwave assisted facile green synthesis of silver and gold nanocatalysts using the leaf extract of Aerva lanata. Spectrochim. Acta Part A Mol. Biomol. Spectrosc. 2015, 136, 1371–1379. [Google Scholar] [CrossRef] [PubMed]
- Jagtap, U.B.; Bapat, V.A. Green synthesis of silver nanoparticles using Artocarpus heterophyllus Lam. seed extract and its antibacterial activity. Ind. Crop. Prod. 2013, 46, 132–137. [Google Scholar] [CrossRef]
- Awwad, A.M.; Salem, N.M.; O Abdeen, A. Green synthesis of silver nanoparticles using carob leaf extract and its antibacterial activity. Int. J. Ind. Chem. 2013, 4, 29. [Google Scholar] [CrossRef]
- Raj, S.; Mali, S.C.; Trivedi, R. Green synthesis and characterization of silver nanoparticles using Enicostemma axillare (Lam.) leaf extract. Biochem. Biophys. Res. Commun. 2018, 503, 2814–2819. [Google Scholar] [CrossRef] [PubMed]
- Singh, P.; Kim, Y.-J.; Wang, C.; Mathiyalagan, R.; Yang, D.-C. The development of a green approach for the biosynthesis of silver and gold nanoparticles by using Panax ginseng root extract, and their biological applications. Artif. Cells Nanomed. Biotechnol. 2015, 44, 1–8. [Google Scholar] [CrossRef]
- Aziz, N.; Faraz, M.; Pandey, R.; Shakir, M.; Fatma, T.; Varma, A.; Barman, I.; Prasad, R. Facile Algae-Derived Route to Biogenic Silver Nanoparticles: Synthesis, Antibacterial, and Photocatalytic Properties. Langmuir 2015, 31, 11605–11612. [Google Scholar] [CrossRef] [PubMed]
- Jayapriya, M.; Dhanasekaran, D.; Arulmozhi, M.; Nandhakumar, E.; Senthilkumar, N.; Sureshkumar, K. Green synthesis of silver nanoparticles using Piper longum catkin extract irradiated by sunlight: Antibacterial and catalytic activity. Res. Chem. Intermed. 2019, 45, 3617–3631. [Google Scholar] [CrossRef]
- Haque, M.A.; Hossain, M.S.; Akanda, R.; Naher, S. Procedure Optimization of Limonia acidissima Leaf Extraction and Silver Nanoparticle Synthesis for Prominent Antibacterial Activity. Chem. Sel. 2019, 4, 14276–14280. [Google Scholar] [CrossRef]
- Allafchian, A.; Mirahmadi-Zare, S.Z.; Jalali, S.A.H.; Hashemi, S.S.; Vahabi, M.R. Green synthesis of silver nanoparticles using phlomis leaf extract and investigation of their antibacterial activity. J. Nanostruct. Chem. 2016, 6, 129–135. [Google Scholar] [CrossRef]
- Naraginti, S.; Li, Y. Preliminary investigation of catalytic, antioxidant, anticancer and bactericidal activity of green synthesized silver and gold nanoparticles using Actinidia deliciosa. J. Photochem. Photobiol. B Biol. 2017, 170, 225–234. [Google Scholar] [CrossRef] [PubMed]
- Moodley, J.S.; Krishna, S.B.N.; Pillay, K.; Sershen, G.P. Green synthesis of silver nanoparticles from Moringa oleifera leaf extracts and its antimicrobial potential. Adv. Nat. Sci. Nanosci. Nanotechnol. 2018, 9, 015011. [Google Scholar] [CrossRef]
- Ajitha, B.; Reddy, Y.A.K.; Reddy, P.S. Green synthesis and characterization of silver nanoparticles using Lantana camara leaf extract. Mater. Sci. Eng. C 2015, 49, 373–381. [Google Scholar] [CrossRef]
- Sana, S.S.; Dogiparthi, L.K. Green synthesis of silver nanoparticles using Givotia moluccana leaf extract and evaluation of their antimicrobial activity. Mater. Lett. 2018, 226, 47–51. [Google Scholar] [CrossRef]
- Shao, Y.; Wu, C.; Wu, T.; Yuan, C.; Chen, S.; Ding, T.; Ye, X.; Hu, Y. Green synthesis of sodium alginate-silver nanoparticles and their antibacterial activity. Int. J. Biol. Macromol. 2018, 111, 1281–1292. [Google Scholar] [CrossRef]
- Rastogi, L.; Arunachalam, J. Sunlight based irradiation strategy for rapid green synthesis of highly stable silver nanoparticles using aqueous garlic (Allium sativum) extract and their antibacterial potential. Mater. Chem. Phys. 2011, 129, 558–563. [Google Scholar] [CrossRef]
- Kumar, V.; Singh, D.K.; Mohan, S.; Gundampati, R.K.; Hasan, S.H. Photoinduced green synthesis of silver nanoparticles using aqueous extract of Physalis angulata and its antibacterial and antioxidant activity. J. Environ. Chem. Eng. 2017, 5, 744–756. [Google Scholar] [CrossRef]
- Ahmad, T.; Bustam, M.A.; Irfan, M.; Moniruzzaman, M.; Asghar, H.M.A.; Bhattacharjee, S. Mechanistic investigation of phytochemicals involved in green synthesis of gold nanoparticles using aqueous Elaeis guineensis leaves extract: Role of phenolic compounds and flavonoids. Biotechnol. Appl. Biochem. 2019, 66, 698–708. [Google Scholar] [CrossRef]
- Jain, S.; Mehata, M.S. Medicinal Plant Leaf Extract and Pure Flavonoid Mediated Green Synthesis of Silver Nanoparticles and their Enhanced Antibacterial Property. Sci. Rep. 2017, 7, 15867. [Google Scholar] [CrossRef]
Sample Availability: Samples of the compounds are not available from the authors. |

| Angle (2θ) | Crystal Plane | Crystallite Size (nm) | Average Crystallite Size (nm) | |
|---|---|---|---|---|
| AuNPs | For Assigned Peaks | For All Peaks | ||
| 38.24° | (111) | 14.6771 | 13.30 | 28.94 |
| 44.42° | (200) | 10.4037 | ||
| 64.86° | (210) | 14.1245 | ||
| 77.67° | (310) | 13.88495 | ||
| AgNPs | ||||
| 27.96° | (210) | 36.9316 | 22.48 | 25.90 |
| 32.34° | (122) | 33.87558 | ||
| 38.19° | (111) | 13.58693 | ||
| 44.47° | (200) | 12.30437 | ||
| 46.35° | (231) | 27.33936 | ||
| 64.48° | (220) | 17.02006 | ||
| 57.98° | (241) | 28.95996 | ||
| 77.47° | (311) | 9.853864 | ||
| Pathogens | Zone of Inhibition (mm) | |
|---|---|---|
| AgNPs (25 µL/26.96 µg) | Ciprofloxacin (10 µL/25 µg) | |
| Escherichia Coli | 18 | 40 |
| Citrobacter freundii | 16 | 37 |
| Bacillus Subtilis | 14 | 35 |
| Pseudomonus aerugenosa | 20 | 35 |
| Salmonella Typhimurium | 17 | 40 |
| Staphylococcus Aureus | 13 | 32 |
Publisher’s Note: MDPI stays neutral with regard to jurisdictional claims in published maps and institutional affiliations. |
© 2020 by the authors. Licensee MDPI, Basel, Switzerland. This article is an open access article distributed under the terms and conditions of the Creative Commons Attribution (CC BY) license (http://creativecommons.org/licenses/by/4.0/).
Share and Cite
Nayem, S.M.A.; Sultana, N.; Haque, M.A.; Miah, B.; Hasan, M.M.; Islam, T.; Hasan, M.M.; Awal, A.; Uddin, J.; Aziz, M.A.; et al. Green Synthesis of Gold and Silver Nanoparticles by Using Amorphophallus paeoniifolius Tuber Extract and Evaluation of Their Antibacterial Activity. Molecules 2020, 25, 4773. https://doi.org/10.3390/molecules25204773
Nayem SMA, Sultana N, Haque MA, Miah B, Hasan MM, Islam T, Hasan MM, Awal A, Uddin J, Aziz MA, et al. Green Synthesis of Gold and Silver Nanoparticles by Using Amorphophallus paeoniifolius Tuber Extract and Evaluation of Their Antibacterial Activity. Molecules. 2020; 25(20):4773. https://doi.org/10.3390/molecules25204773
Chicago/Turabian StyleNayem, S. M. Abu, Nasrin Sultana, Md. Aminul Haque, Billal Miah, Md. Mahmodul Hasan, Tamanna Islam, Md. Mahedi Hasan, Abdul Awal, Jamal Uddin, Md. Abdul Aziz, and et al. 2020. "Green Synthesis of Gold and Silver Nanoparticles by Using Amorphophallus paeoniifolius Tuber Extract and Evaluation of Their Antibacterial Activity" Molecules 25, no. 20: 4773. https://doi.org/10.3390/molecules25204773
APA StyleNayem, S. M. A., Sultana, N., Haque, M. A., Miah, B., Hasan, M. M., Islam, T., Hasan, M. M., Awal, A., Uddin, J., Aziz, M. A., & Ahammad, A. J. S. (2020). Green Synthesis of Gold and Silver Nanoparticles by Using Amorphophallus paeoniifolius Tuber Extract and Evaluation of Their Antibacterial Activity. Molecules, 25(20), 4773. https://doi.org/10.3390/molecules25204773

